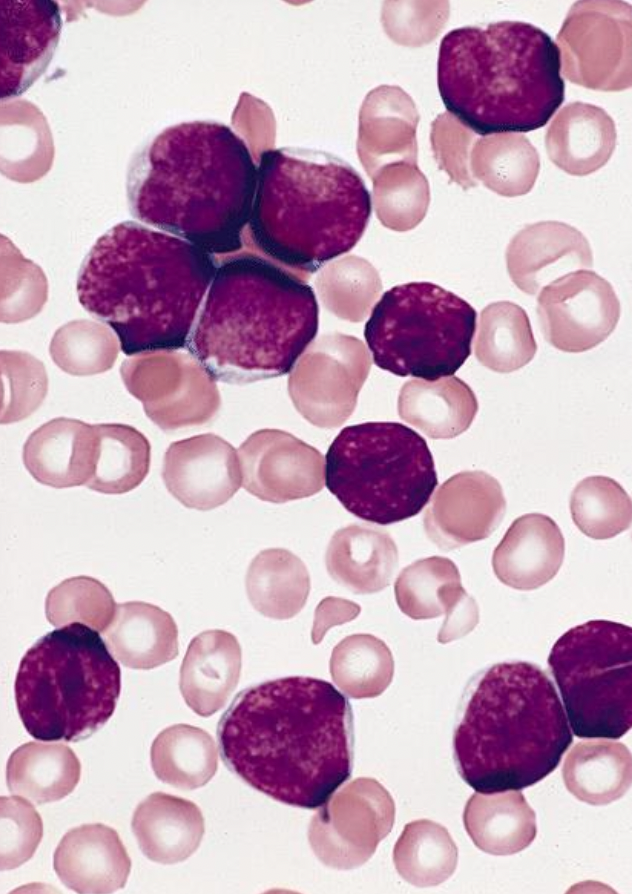
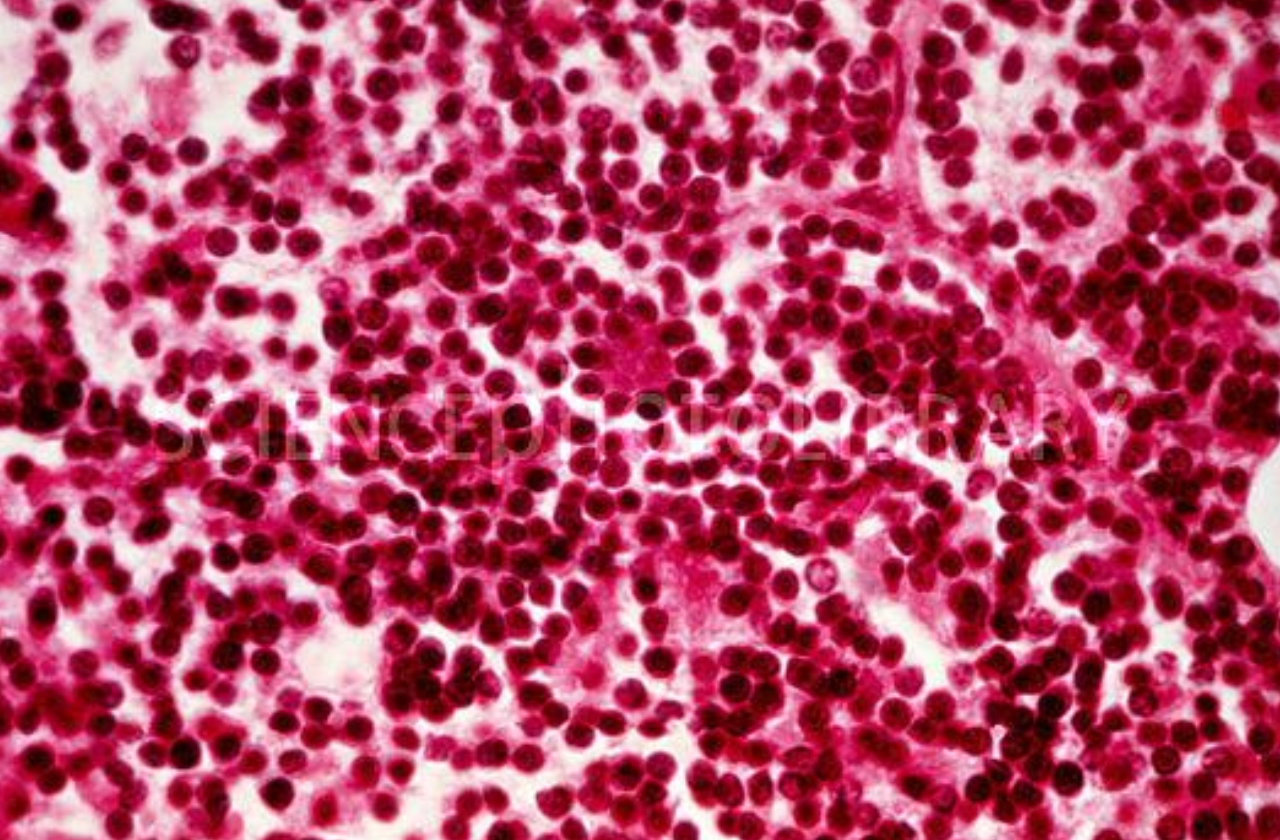
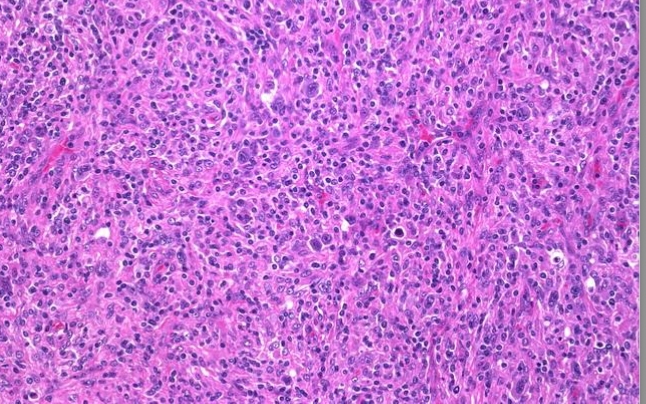

Leukemias and Lymphomas
Pathogenic defect is a block in differentiation causing maturation arrest from acquired mutations in lineage- specific transcription factor genes
80-85% are ___ in origin
B-cell
Lymphomas present as ___
painless masses
Leukemias present due to ___
marrow replacement
-anemia
-leukopenia
-thrombocytopenia
Leukemias
2% of cancers
-specific cell markers and genetic abnormalities
Acute Lymphoblastic Leukemia
70% of childhood leukemias
-mostly precursor B cell lymphoblasts in bone and marrow
Lymphoblasts in blood

Lymphoblasts in bone marrow
Chronic Lymphocytic Leukemia
-30% of adult leukemias
-proliferation of mature lymphocytes mostly in blood
-10 yr survival
-SLL/CLL
Small mature lymphocytes, but way too many in blood and bone marrow
Acute Myeloblastic Leukemia
-mostly older pts
-WBC > 100k
-Karyotyping clinically predictive
Chronic Myeloid Leukemia
-170k WBC
-Metamyelocytes/myelocytes/bands
-Chr T 9, 22
-Blast crisis termination
Hodgkin’s Lymphoma
-Reed Sternberg Cell
-Germinal center B cell origin
-Spreads by continuity

Reed Sternberg Cell
Hodgkins Lymphoma Staging
1: single lymph node
2: two lymph nodes, same side
3: both sides of diaphragm +/- spleen
4: multiple/disseminated (A=no fever, B=fever)

Hodgkins Lymphoma involving Liver
Nodular Sclerosis
most common HL
-young ppl
-good prognosis
Mixed cellularity
M > F, above 50
-disseminated with symps
Lymphocyte Predominant
younger males
-5% of HL
HL Mixed Cellularity
Lymphoma Grades
-Indolent, Low grade (long survival, never cured)
-Aggressive, High grade (high death, curable)

Follicular Lymphoma
SLL vs CLL
in CLL bone marrow involvement exceeds lymph nodes, and in SLL it’s the reverse

Diffuse Large B cell Lymphomas, 50% of lymphomas in adults


